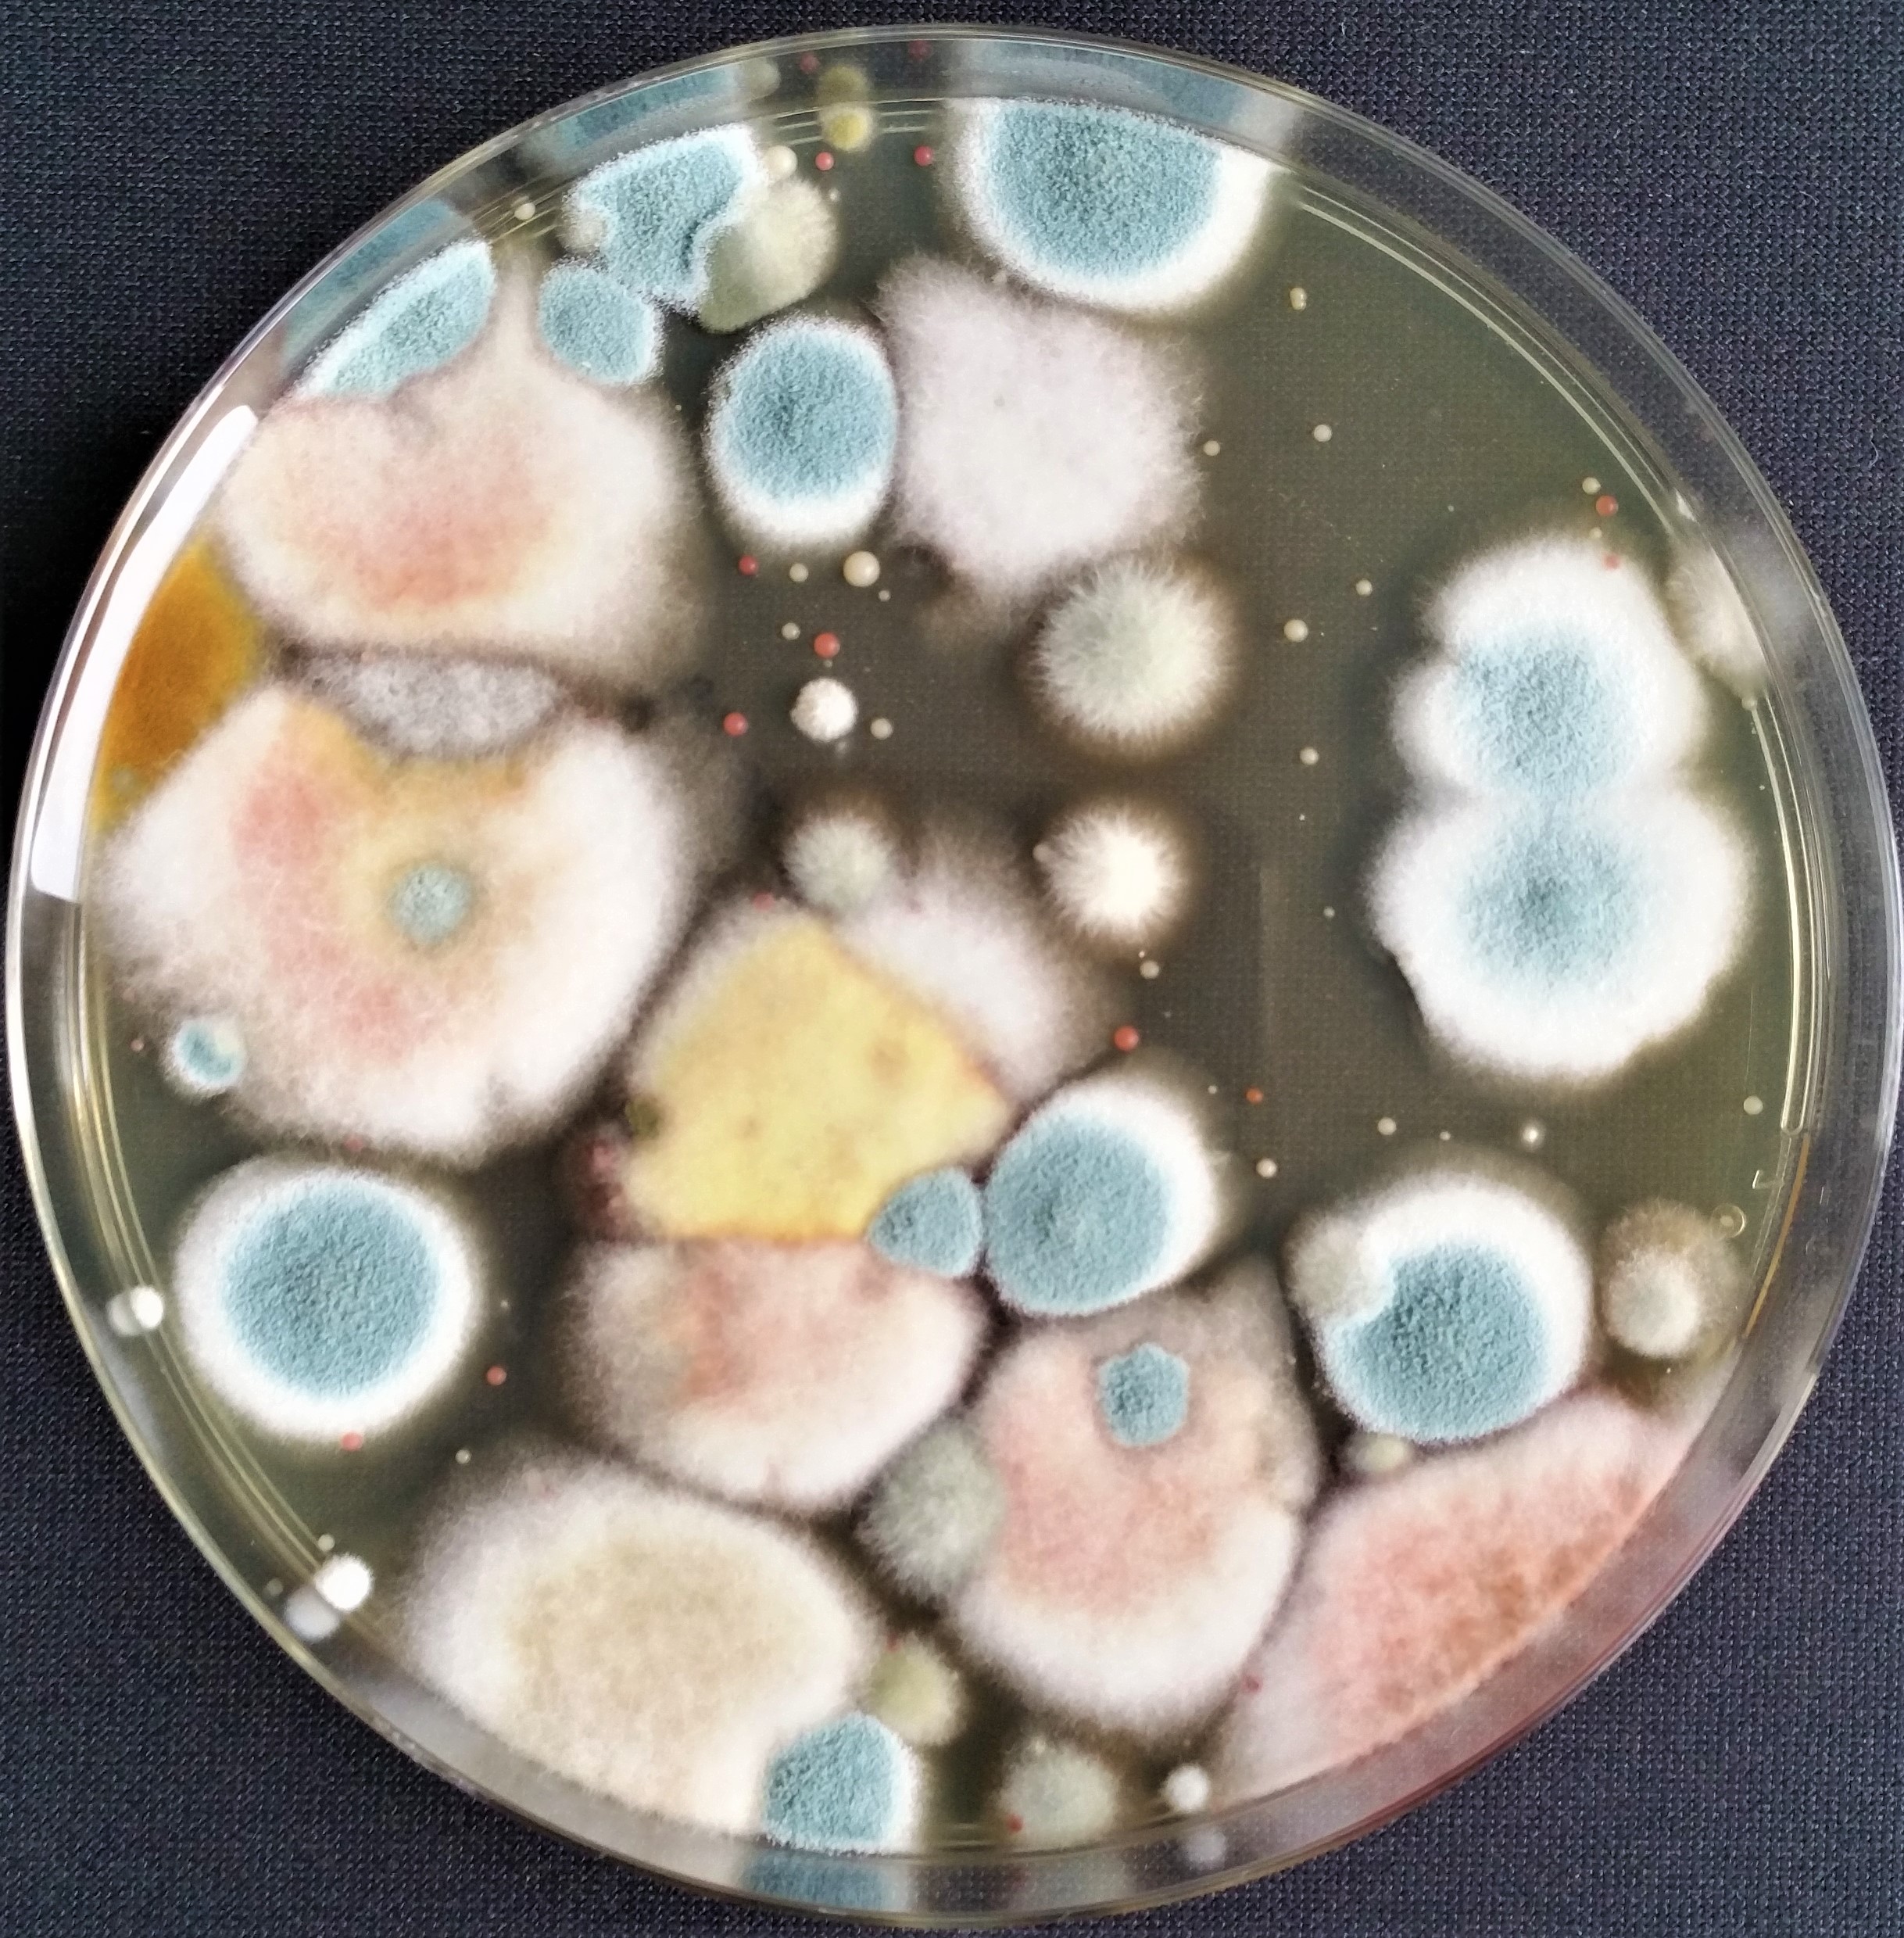
Wasser-Luft-Check, Äußere Oberaustr. 36/4 in Rosenheim

Wasser-Luft-Check
in Rosenheim
Lokales Geschäft
Adresse
Äußere Oberaustr. 36/483026 Rosenheim Zur Webseite
Kontakt
Telefonnummer: 080317967705
Fax: 080317967708
E-Mail: info@walucheck.de
Öffnungszeiten
Mo. 08:00 - 18:00Di. 08:00 - 18:00
Mi. 08:00 - 18:00
Do. 08:00 - 18:00
Fr. 08:00 - 18:00
Sa. Geschlossen
So. Geschlossen